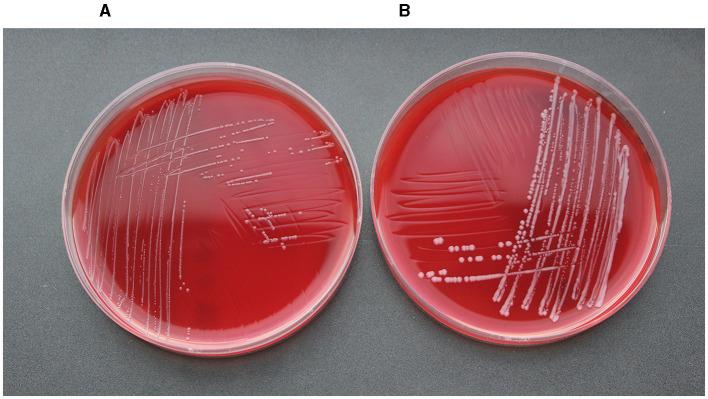
https://cdn.ncbi.nlm.nih.gov/pmc/blobs/ced3/10940430/5473d968e9f3/fmicb-15-1356208-g0004.jpg

2009年至2020年德国国家耐药性监测项目GE-Vet中与牛呼吸道疾病相关的分离株对大环内酯类药物的耐药性
Macrolide resistance in isolates associated with bovine respiratory disease from the German national resistance monitoring program GE-Vet 2009 to 2020.
作者信息
Kostova Valeria, Hanke Dennis, Kaspar Heike, Fiedler Stefan, Schwarz Stefan, Krüger-Haker Henrike
机构信息
Institute of Microbiology and Epizootics, Centre for Infection Medicine, School of Veterinary Medicine, Freie Universität Berlin, Berlin, Germany.
Veterinary Centre for Resistance Research (TZR), School of Veterinary Medicine, Freie Universität Berlin, Berlin, Germany.
出版信息
Front Microbiol. 2024 Mar 1;15:1356208. doi: 10.3389/fmicb.2024.1356208. eCollection 2024.
Data collected from the German national resistance monitoring program GE-Vet showed slowly increasing prevalence of macrolide resistance among bovine respiratory disease (BRD)-associated from cattle over the last decade. The focus of this study was to analyze the genetic basis of antimicrobial resistance (AMR) and the prevalence of multidrug-resistance (MDR)-mediating integrative and conjugative elements (ICEs) in 13 German BRD-associated isolates collected between 2009 and 2020 via whole-genome sequencing. Antimicrobial susceptibility testing (AST) was performed via broth microdilution according to the recommendations of the Clinical and Laboratory Standards Institute for the macrolides erythromycin, tilmicosin, tulathromycin, gamithromycin, tildipirosin, and tylosin as well as 25 other antimicrobial agents. All isolates either had elevated MICs or were resistant to at least one of the macrolides tested. Analysis of whole-genome sequences obtained by hybrid assembly of Illumina MiSeq and Oxford Nanopore MinION reads revealed the presence of seven novel Tn-like ICEs, designated Tn, and Tn- Tn. These ICEs harbored the antimicrobial resistance genes (T), (C), (G), (Y), and in different combinations. In addition, mutational changes conferring resistance to macrolides, nalidixic acid or streptomycin, respectively, were detected among the . isolates. In addition, four isolates carried a 4,613-bp plasmid with the β-lactamase gene . The detection of the macrolide resistance genes (T), (C), and (G) together with other resistance genes on MDR-mediating ICEs in bovine may explain the occurrence of therapeutic failure when treating BRD with regularly used antimicrobial agents, such as phenicols, penicillins, tetracyclines, or macrolides. Finally, pathogen identification and subsequent AST is essential to ensure the efficacy of the antimicrobial agents applied to control BRD in cattle.
从德国国家耐药性监测项目GE-Vet收集的数据显示,在过去十年中,牛呼吸道疾病(BRD)相关的牛群中,大环内酯类耐药性的流行率呈缓慢上升趋势。本研究的重点是通过全基因组测序分析2009年至2020年间收集的13株德国BRD相关分离株中抗菌药物耐药性(AMR)的遗传基础以及介导多重耐药性(MDR)的整合和接合元件(ICEs)的流行情况。根据临床和实验室标准协会的建议,通过肉汤微量稀释法对大环内酯类药物红霉素、替米考星、泰拉霉素、加米霉素、替地罗新和泰乐菌素以及其他25种抗菌药物进行药敏试验。所有分离株要么最低抑菌浓度(MIC)升高,要么对至少一种测试的大环内酯类药物耐药。对通过Illumina MiSeq和Oxford Nanopore MinION读数的混合组装获得的全基因组序列分析显示,存在7种新型Tn样ICEs,分别命名为Tn、Tn - Tn。这些ICEs含有不同组合的抗菌耐药基因(T)、(C)、(G)、(Y)和。此外,在这些分离株中分别检测到了导致对大环内酯类药物、萘啶酸或链霉素耐药的突变变化。此外,4株分离株携带一个带有β-内酰胺酶基因的4613 bp质粒。在牛的多重耐药介导ICEs上检测到大环内酯类耐药基因(T)、(C)和(G)以及其他耐药基因,这可能解释了在使用常规抗菌药物如酚类、青霉素、四环素或大环内酯类治疗BRD时出现治疗失败的原因。最后,病原体鉴定和随后的药敏试验对于确保应用于控制牛BRD的抗菌药物的疗效至关重要。